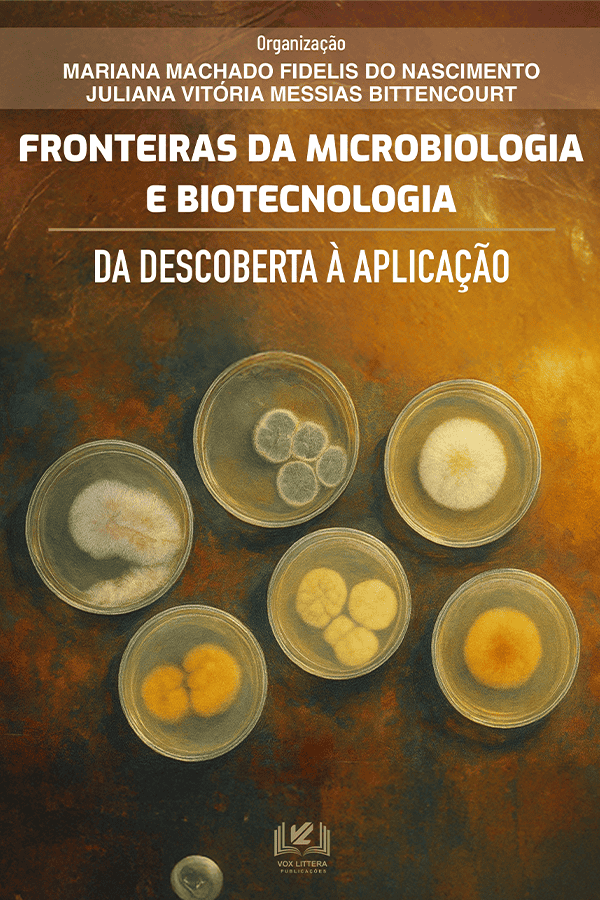

Equipe técnica e Conselho editorial reconhecidos
Seu trabalho despontando no mundo acadêmico
Sua obra publicada com certificação DOI e ISBN
As melhores condições para você publicar
VOX LITTERA, uma nova proposta editorial
Prezamos o conhecimento e a divulgação científica acima de tudo, utilizando a tecnologia e as melhores ferramentas para atender nossos caríssimos leitores e proeminentes escritores.
"Descubra a razão que comanda você a escrever; veja se ela espalhou suas raízes no fundo do seu coração; confesse a si mesmo que você teria que morrer se você fosse proibido de escrever.“
Rainer Maria Rilke
Uma editora acadêmica
A VOX LITTERA tem um sério compromisso com os livros que publica pois eles carregam não apenas o nome da editora, mas, ainda, sua filosofia de trabalho e a de todos os seus colaboradores. É um compromisso social e com a humanidade.
Desde a escolha de um corpo editorial altamente qualificado, até a gramatura do papel que se usará, o processo de cada obra é único e seguido atentamente pela VOX LITTERA, para que a primeira satisfação seja de seu escritor e perdure em cada um dos leitores.
Conheça o que temos para oferecer!
Nossos serviços
Editoração
Consultoria editorial
Design e Arte
Marketing Editorial
Publicação
Normatização ABNT e APA
Revisão e Tradução
Diagramação
reconhecimento acadêmico
INDEXADORES










DISTRIBUIÇÃO EFICIENTE
SUAS OBRAS FÍSICAS OU E-BOOKS NAS MELHORES LOJAS










ENTRE EM CONTATO CONOSCO
VAMOS PUBLICAR SUA OBRA JUNTOS?
ENTRE EM CONTATO CONOSCO!
Tem alguma dúvida? Mande uma mensagem para nós e vamos conversar!
Ligue para nós
(44) 3367-8483
CONTATO@VOXLITTERA.COM.BR
(44) 9.8809-1333